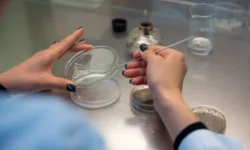
ДВФУ, ТГМУ и МГУ объединились для научного прорыва в Приоритете-2030 dvfu tgmu i mgu obedinilis dlya nauchnogo proryva v prioritete2030-fabrec-ru-0

Популярная книга «Век русских конструкторов. Истории выдающихся изобретений и их создателей» снова доступна для читателей благодаря дополнительному тиражу. Это издание впервые появилось прошлой осенью и сразу привлекло внимание всех, кто интересуется историей технического прогресса нашей страны.
Легендарные имена и судьбы российских гениев
Книга рассказывает о судьбах выдающихся инженеров и новаторов, чьи труды стояли у истоков многих успешных проектов и играли ключевую роль в развитии отечественной науки и техники. Читатели смогут погрузиться в уникальную атмосферу жизни и работы создателей таких знаменитых изобретений, как винтовка Мосина, легендарный танк Т-34, штурмовик Ил-2, первый в мире самолет и мощный атомный реактор.
Особое внимание уделяется деталям эпохи: как жили инженеры и учёные, с какими трудностями сталкивались на пути к своим открытиям, как рождались идеи, которые перевернули представление о возможностях техники. Их вклад в техническое оснащение страны не только изменил ход истории, но и стал гордостью для целых поколений.
Вдохновляющие истории и новые открытия
В каждой главе этой книги открывается не только описание разработок, но и живые, эмоциональные рассказы о людях, которыми двигала мечта и стремление сделать мир вокруг лучше. Талант, самоотверженность, вера в собственные силы и любовь к родине позволили им не просто изобретать, а создавать целые направления, имена которых золотыми буквами вписаны в историю страны.
«Век русских конструкторов» — это источник вдохновения для всех, кто верит в силу инженерной мысли и ценит исторический опыт. Новое издание открывает широкому кругу читателей доступ к этим удивительным биографиям и доказывает, что талант и энергия отечественных конструкторов по-прежнему являются гордостью для России. Книга приглашает прикоснуться к хронике триумфов и преодолений, показать, как русские инженеры и изобретатели смогли добиться признания и оставить яркий след в мировой науке и технике.
Эта книга станет отличным выбором для всех, кто интересуется достижениями страны, ищет настоящие примеры мужества, упорства и вдохновения. Не упустите возможность открыть для себя удивительный «Век русских конструкторов» — историю великих изобретателей, прославивших Россию своими гениальными идеями.
Источник: russian.rt.com